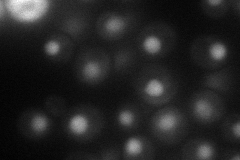
YLL019C
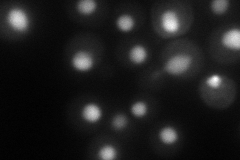
YLL019C
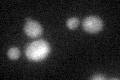
YLL019C

View description
Nonessential putative protein kinase of unknown cellular role; member of the LAMMER family of protein kinases, which are serine/threonine kinases also capable of phosphorylating tyrosine residues
Localization:
Intensity:
Fold change:
Significance:
-
C’ GFP library in SD

below threshold18.37 -
N' NOP1pr-GFP in SD
nucleus62.8138 -
N' TEF2pr-mCherry in SD
nucleus78.6165 -
N' NATIVEpr-GFP in SD

nucleus26.9496 -
N' TEF2pr-VC and Cyto-VN in SD

#N/A0 -
C’ GFP library in SD+DTT
cytosol17.230.93No -
C’ GFP library in SD+H2O2

cytosol18.290.99No -
C’ GFP library in Starvation Media

cytosol16.390.89No -
C’ GFP library on the background of Pup2-DaMP

below threshold -
C’ GFP library on the background of CCT mutant

below threshold19.07261.03802No
